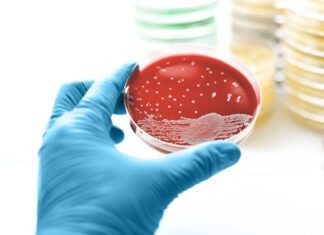
Pseudomonas aeruginosa: Огляд інфекції, ризики та профілактика

Деменція — це не лише забування імен чи втрата ключів. Хоча втрата пам’яті є загальною ознакою деяких форм захворювання, ранні ознаки можуть проявлятися несподівано, впливаючи на особистість, соціальні навички та навіть базові судження. Розпізнавання цих незначних змін є критично важливим, оскільки рання діагностика дозволяє краще контролювати стан і планувати майбутнє.
Спектр симптомів деменції
Деменція — це не одне захворювання, а загальний термін для різних когнітивних розладів. Як він проявляється, залежить від конкретного виду. Наприклад, лобно-скронева деменція (ЛСД) часто починається зі змін особистості та поведінки, тоді як деменція з тільцями Леві може викликати галюцинації або дивні нав’язливі ідеї. Хоча хвороба Альцгеймера часто пов’язана з втратою пам’яті, також може починатися з труднощів у мові або зоровому сприйнятті.
Незначні зміни в поведінці, які сигналізують про проблему
Кетрін Ранкін, нейропсихолог з Каліфорнійського університету в Сан-Франциско, наголошує, що будь-яке значне відхилення від нормальної людської поведінки слід досліджувати. Ось десять несподіваних перших ознак, на які варто звернути увагу:
1. Проблеми з водінням і часті падіння
Раптові труднощі з керуванням або помітне збільшення кількості падінь є тривожними сигналами. Падіння – це не просто нещасні випадки; вони можуть бути ранніми симптомами захворювань головного мозку, таких як прогресуючий над’ядерний параліч.
2. Втрата здатності розпізнавати соціальні сигнали
Сарказм і брехня є частиною повсякденних взаємодій, але людям із FTD або хворобою Альцгеймера може бути важко їх розпізнати. Пацієнти з FTD особливо схильні не помічати оманливі сигнали, тоді як пацієнти з хворобою Альцгеймера все ще зберігають цю здатність.
3. Нехтування соціальними нормами та законом
Раптова зміна поведінки, наприклад крадіжка або порушення закону, може бути ранньою ознакою деменції, навіть якщо вона виникає у людини, яка завжди була законослухняною.
4. Погіршення погляду та труднощі з читанням
Люди з деменцією з тільцями Леві можуть демонструвати «опущений погляд», часто дивлячись в одну точку. Вони також можуть пропускати рядки під час читання, що є симптомом, який вони самі можуть не помітити.
5. Плутанина з предметами побуту
Забуття як використовувати звичайні предмети, а не тільки їхні назви, може бути ознакою хвороби Альцгеймера. Людина може знати, що таке вилка, але важко згадати її призначення.
6. Неадекватна поведінка та втрата емпатії
Раптові спалахи грубості або бездушності без докорів сумління можуть свідчити про лобно-скроневу деменцію. Здатність читати соціальні сигнали та розуміти, чому певна поведінка є неприйнятною, знижується на ранніх стадіях захворювання.
7. Компульсивна поведінка та ритуали
Надзвичайне накопичення або компульсивні ритуали, такі як купівля кількох копій одного і того ж предмета, можуть бути ранніми симптомами лобно-скроневої деменції.
8. Труднощі з управлінням грошима
Наростання фінансових проблем, таких як ведення банківського рахунку або оплата рахунків, є класичною ранньою ознакою хвороби Альцгеймера. Це не є нормальною частиною старіння; це симптом когнітивного зниження.
9. Труднощі складання слів
Раптові проблеми зі зв’язним мовленням, незважаючи на збереження інших когнітивних здібностей, можуть свідчити про первинну прогресуючу афазію, рідкісну форму деменції.
10. Зміни в особистості
Нехарактерна поведінка, така як підвищена дратівливість, апатія або втрата інтересу до хобі, також може бути ознакою деменції.
Чому важливе раннє розпізнавання
Деменція не завжди починається з втрати пам’яті. Спочатку можуть уражатися різні ділянки мозку, що призводить до широкого діапазону початкових симптомів. Якщо у вас або ваших близьких виявляються будь-які з цих змін, важливо звернутися до лікаря. Раннє виявлення дозволяє вчасно лікувати, підтримувати та планувати майбутнє.